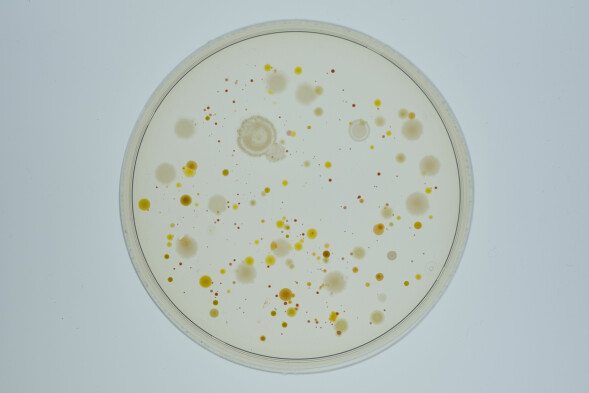

Category: Microorganisms
Speaker: Ian Taylor
Tags: worldview, devotional, creation science, christian radio, creation moments, ian taylor, biblical proof, today’s creation moment, bacteria intelligence
Category: Microorganisms
Speaker: Ian Taylor
Tags: worldview, devotional, creation science, christian radio, creation moments, ian taylor, biblical proof, today’s creation moment, bacteria intelligence
Researchers are learning that bacteria have senses similar to our hearing and sight. Bacteria even have a brain that receives information from their senses. They can make decisions. However, all of this is not enough to explain how bacteria can make the decision to swim toward food.
When you want a candy bar, you know where to find one, even if you must go to the nearest store. You might also hope that your dentist doesn't see you buying candy. All of this involves memory, which has long been considered a basic part of the mind.
Researchers, using various solutions of substances that attract or repel bacteria, have now learned that bacteria do indeed have both long-term and short-term memories. They remember where goodies are to be found. Once a bacterium develops a strategy for dealing with the unknown, it will remember what to do next time.
This finding shocked researchers. They know that when you or I decide to retreat or advance, at least hundreds and probably thousands of brain cells are involved. The one-celled bacteria can make the same decision based on past memories. Are there really "simple" forms of life that serve as the living traces of evolutionary development? Scientists haven't found any yet. According to the Bible's account of creation, we don't expect them to find any simple forms of life from which we can be traced.
Psalm 119:130
"The entrance of thy words giveth light; it giveth understanding unto the simple."
Prayer: Lord, You do things so well that we often mistake Your genius for simplicity. Give me a mind more like Yours, having both love and wisdom. Amen.
Ref: Pietsch, Paul. "The mind of a microbe." Science Digest.
